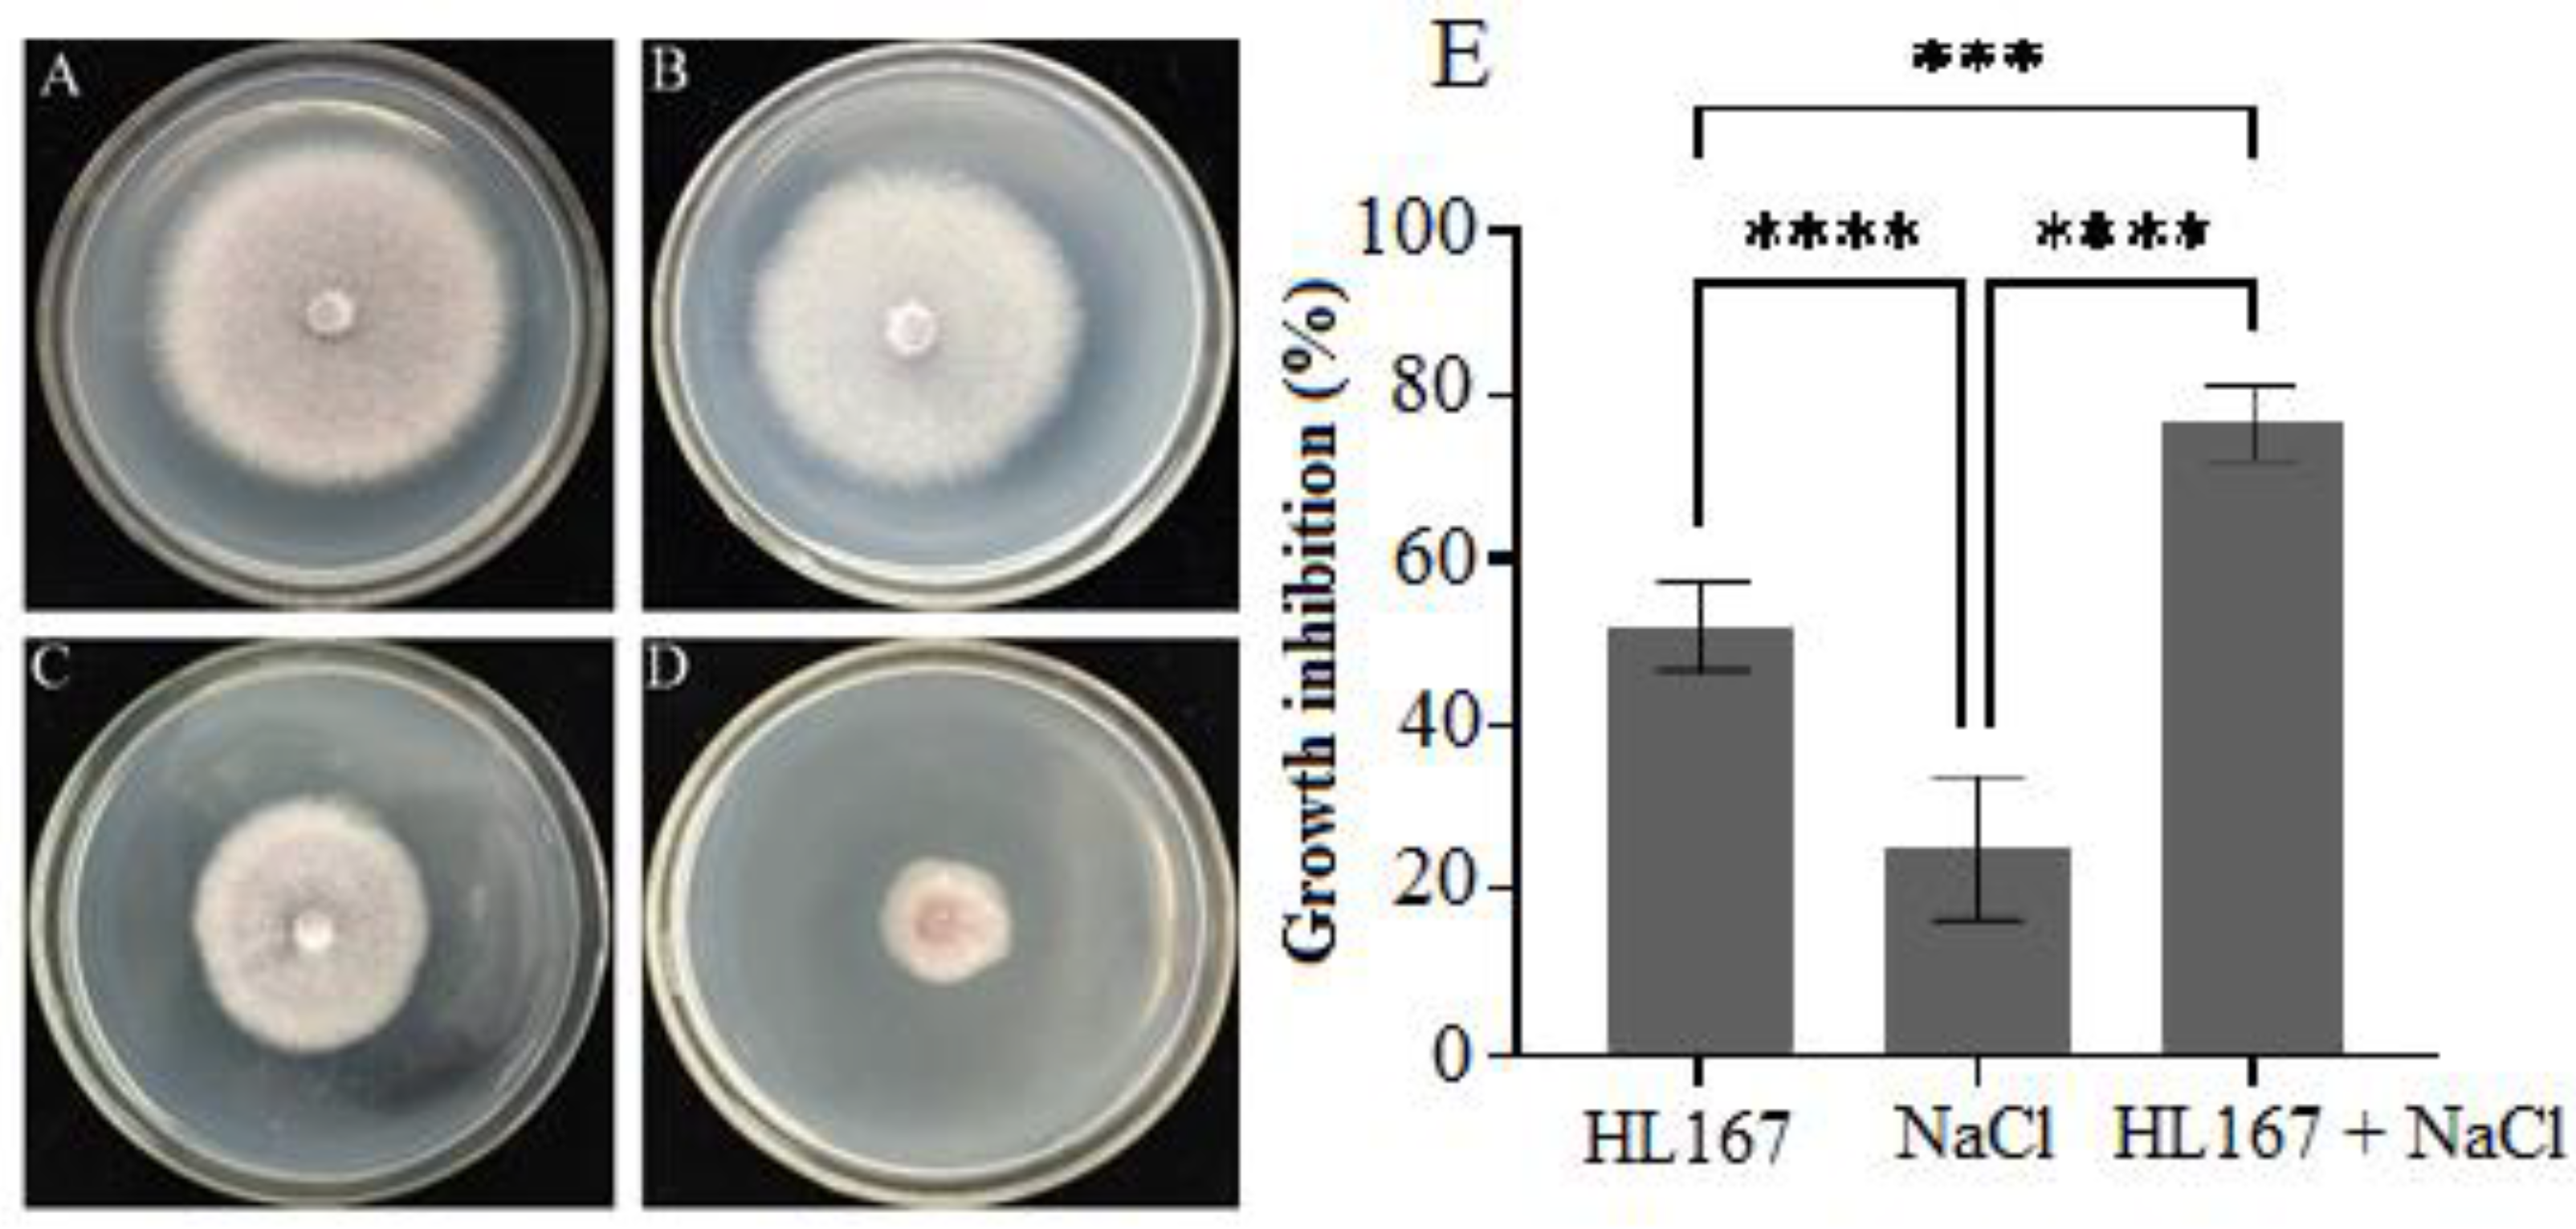
Jof 09 00304 g007 Jof 09 00304 g007

A Salt-Tolerant Strain of Trichoderma longibrachiatum HL167 Is Effective in Alleviating Salt Stress, Promoting Plant Growth, and Managing Fusarium Wilt Disease in Cowpea
Abstract
1. Introduction
2. Materials and Methods
2.1. Pathogen Strain
2.2. Isolation of Trichoderma spp.
2.3. Screening of Trichoderma Isolate for Salt Tolerance Capacity and Antagonistic Activity
2.4. Morphological and Molecular Identification of the Trichoderma HL167
2.5. Scanning Electron Microscopic Analysis
2.6. Trichoderma HL167 Antagonistic Activity under 200 mM NaCl
2.7. Antifungal Metabolite Production Test
2.8. In Vivo Evaluation of T. Longibrachiatum HL167 for Alleviating Salt Stress in Cowpea
2.9. Evaluation of the Colonization Ability of Trichoderma HL167 on Cowpea Seedlings
2.10. Field Evaluation of Trichoderma HL167 for the Management of F. oxysporum in Cowpea
2.10.1. Trichoderma HL167 Spore Solution Fermentation and F. oxysporum Spore Suspension
2.10.2. Field Experiment and Treatment Allocation
2.10.3. Measurement of Disease Index and Preventive Effect
2.11. Statistical Analysis
3. Results
3.1. Isolation of Trichoderma Isolates and Their Salt Tolerance Ability
3.2. Antagonistic Activity of Salt-Tolerant Trichoderma Strains against F. oxysporum
3.3. Phenotypic Assays and Molecular Identification
3.4. Trichoderma HL167 Antagonistic Activity under 200 mM NaCl
3.4.1. Dual Culture
3.4.2. SEM Analysis
3.4.3. Metabolites Mediated Antifungal Test
3.5. Effect of T. longibrachiatum HL167 on the Growth and Chlorophyll Content of Cowpea Plants under Salt Stress
3.6. T. longibrachiatum HL167 Induced the Expression Defense Response-Related Enzyme Activity in Cowpea under Salt Stress
3.7. Na+ and K+ Measurements
3.8. Trichoderma HL167 Colonization on Cowpea Seedlings
3.9. Evaluation of the Control Effect of Trichoderma HL167 on F. oxysporum
4. Discussion
5. Conclusions
Supplementary Materials
Author Contributions
Funding
Institutional Review Board Statement
Informed Consent Statement
Data Availability Statement
Conflicts of Interest
References
- Oney-Birol, S. Exogenous L-carnitine promotes plant growth and cell division by mitigating genotoxic damage of salt stress. Sci. Rep. 2019, 9, 17229. [Google Scholar] [CrossRef] [PubMed]
- Yang, W.; Jiao, Y.; Yang, M.; Wen, H.; Liu, L. Absorbed carbon dioxide in saline soil from northwest China. Catena 2021, 207, 105677. [Google Scholar] [CrossRef]
- Huang, X.; Yang, L.; Jin, Y.; Lin, J.; Liu, F. Generation, annotation, and analysis of a large-scale expressed sequence tag library from Arabidopsis pumila to explore salt-responsive genes. Front. Plant Sci. 2017, 8, 955. [Google Scholar] [CrossRef]
- Loudari, A.; Benadis, C.; Naciri, R.; Soulaimani, A.; Zeroual, Y.; Gharous, M.E.; Kalaji, H.M.; Oukarroum, A. Salt stress affects mineral nutrition in shoots and roots and chlorophyll a fluorescence of tomato plants grown in hydroponic culture. J. Plant Interact. 2020, 15, 398–405. [Google Scholar] [CrossRef]
- Sun, J.; He, L.; Li, T. Response of seedling growth and physiology of Sorghum bicolor (L.) Moench to saline-alkali stress. PLoS ONE 2019, 14, e0220340. [Google Scholar] [CrossRef]
- Yang, H.; Du, T.; Mao, X.; Ding, R.; Shukla, M.K. A comprehensive method of evaluating the impact of drought and salt stress on tomato growth and fruit quality based on EPIC growth model. Agric. Water Manag. 2019, 213, 116–127. [Google Scholar] [CrossRef]
- Siddiqui, M.H.; Al-Whaibi, M.H.; Basalah, M.O. Role of nitric oxide in tolerance of plants to abiotic stress. Protoplasma 2011, 248, 447–455. [Google Scholar] [CrossRef]
- Katiyar, D.; Hemantaranjan, A.; Singh, B. Chitosan as a promising natural compound to enhance potential physiological responses in plant: A review. Ind. J. Plant Physiol. 2015, 20, 1–9. [Google Scholar] [CrossRef]
- Tian, X.; He, M.; Wang, Z.; Zhang, J.; Song, Y.; He, Z.; Dong, Y. Application of nitric oxide and calcium nitrate enhances tolerance of wheat seedlings to salt stress. Plant Growth Regul. 2015, 77, 343–356. [Google Scholar] [CrossRef]
- Aydogan, C.; Turhan, E. Influence of exogenous ascorbic acid application on antioxidative responses and protein profile of green bean to salt stress. J. Biotechnol. 2018, 280, S86. [Google Scholar] [CrossRef]
- Doehlemann, G.; Ökmen, B.; Zhu, W.; Sharon, A. Plant pathogenic fungi. Microbiol. Spectr. 2017, 5, 703–726. [Google Scholar] [CrossRef] [PubMed]
- Khan, R.A.A.; Najeeb, S.; Mao, Z.; Ling, J.; Yang, Y.; Li, Y.; Xie, B. Bioactive secondary metabolites from Trichoderma spp. against phytopathogenic bacteria and root-knot nematode. Microorganisms 2020, 8, 401. [Google Scholar] [CrossRef] [PubMed]
- Dubey, S.C.; Suresh, M.; Singh, B. Evaluation of Trichoderma species against Fusarium oxysporum f. sp. ciceris for integrated management of chickpea wilt. Biol. Control 2007, 40, 118–127. [Google Scholar] [CrossRef]
- Sun, S.; Zhu, L.; Sun, F.; Duan, C.; Zhu, Z. Pathotype diversity of Fusarium oxysporum f. sp. mungcola causing wilt on mungbean (Vigna radiata). Crop Pasture Sci. 2020, 71, 873–883. [Google Scholar] [CrossRef]
- Berger, L.R.R.; Stamford, N.P.; Willadino, L.G.; Laranjeira, D.; Lima, M.A.B.; Malheiros, S.M.M.; Oliveira, W.J.; Stamford, T.C.M. Cowpea resistance induced against Fusarium oxysporum f.sp. tracheiphilum by crustaceous chitosan and by biomass and chitosan obtained from Cunninghamella elegans. Biol. Control 2016, 92, 45–54. [Google Scholar] [CrossRef]
- Redkar, A.; Sabale, M.; Schudoma, C.; Zechmann, B.; Gupta, Y.K.; López-Berges, M.S.; Giovanni, V.; Selena, G.I.; David, T.; Roberto, S. Conserved secreted effectors contribute to endophytic growth and multihost plant compatibility in a vascular wilt fungus. Plant Cell 2022, 34, 3214–3232. [Google Scholar] [CrossRef]
- Dong, J.; Song, Y.; Wang, B.; Wu, X.; Wang, Y.; Wang, J.; Lu, Z.; Zhang, Y.; Li, G.; Wu, X.; et al. Identification of genomic regions associated with Fusarium wilt resistance in cowpea. Appl. Sci. 2022, 12, 6889. [Google Scholar] [CrossRef]
- Lecomte, C.; Alabouvette, C.; Edel-Hermann, V.; Robert, F.; Steinberg, C. Biological control of ornamental plant diseases caused by Fusarium oxysporum: A review. Biol. Control 2016, 101, 17–30. [Google Scholar] [CrossRef]
- Brotman, Y.; Landau, U.; Cuadros-Inostroza, A.; Tohge, T.; Fernie, A.; Chet, I.; Viterbo, A.; Willmitzer, L. Trichoderma-plant root colonization: Escaping early plant defense responses and activation of the antioxidant machinery for saline stress tolerance. PLoS Pathog. 2013, 9, e1003221. [Google Scholar] [CrossRef]
- Contreras-Cornejo, H.; Macías-Rodríguez, L.; Cuevas, R.; López-Bucio, J. Trichoderma spp. improve growth of Arabidopsis seedlings under salt stress through enhanced root development, osmolite production, and Na+ elimination through root exudates. Mol. Plant Microbe Interact. 2014, 27, 503–514. [Google Scholar] [CrossRef]
- Sánchez-Montesinos, B.; Diánez, F.; Moreno-Gavira, A.; Gea, F.J.; Santos, M. Plant growth promotion and biocontrol of Pythium ultimum by saline tolerant Trichoderma isolates under salinity stress. Int. J. Environ. Res. Public Health 2019, 16, 2053. [Google Scholar] [CrossRef] [PubMed]
- Li, M.; Ma, G.; Lian, H.; Su, X.; Tian, Y.; Huang, W.; Mei, J.; Jiang, X.L. The effects of Trichoderma on preventing cucumber Fusarium wilt and regulating cucumber physiology. J. Integr. Agric. 2019, 18, 607–617. [Google Scholar] [CrossRef]
- Díaz-Gutiérrez, C.; Arroyave, C.; Llugany, M.; Poschenrieder, C.; Martos, S.; Pelaez, C. Trichoderma asperellum as a preventive and curative agent to control Fusarium wilt in Stevia rebaudiana. Biol. Control 2021, 155, 104537. [Google Scholar] [CrossRef]
- Rawat, L.; Singh, Y.; Shukla, N.; Kumar, J. Salinity tolerant Trichoderma harzianum reinforces NaCl tolerance and reduces population dynamics of Fusarium oxysporum f. sp. ciceri in chickpea (Cicer arietinum L.) under salt stress conditions. Arch. Phytopathol. Plant Prot. 2013, 46, 1442–1467. [Google Scholar] [CrossRef]
- Kashyap, P.L.; Solanki, M.K.; Kushwaha, P.; Kumar, S.; Srivastava, A.K. Biocontrol potential of salt-tolerant Trichoderma and Hypocrea isolates for the management of tomato root rot under saline environment. J. Soil Sci. Plant Nut. 2020, 20, 160–176. [Google Scholar] [CrossRef]
- Zhang, C.; Wang, W.; Xue, M.; Liu, Z.; Zhang, Q.; Hou, J.; Liu, T. The combination of a biocontrol agent Trichoderma asperellum SC012 and hymexazol reduces the effective fungicide dose to control Fusarium wilt in cowpea. J. Fungi 2021, 7, 685. [Google Scholar] [CrossRef]
- Samuels, G.J.; Hebbar, P.K. Trichoderma: Identification and Agricultural Applications; American Phytopathological Society: Saint Paul, MN, USA, 2015. [Google Scholar]
- Kumar, M.S.; Kaur, G.; Sandhu, A.K. Genomic DNA isolation from fungi, algae, plant, bacteria and human blood using CTAB. Int. J. Sci. Res. 2014, 9, 617–618. [Google Scholar]
- Carbone, I.; Kohn, L.M. A method for designing primer sets for speciation studies in filamentous ascomycetes. Mycologia 1999, 91, 553–556. [Google Scholar] [CrossRef]
- Jaklitsch, W.M.; Komon, M.; Kubicek, C.P.; Druzhinina, I.S. Hypocrea voglmayrii sp. Nov. from the Austrian Alps represents a new phylogenetic clade in Hypocrea/Trichoderma. Mycologia 2005, 97, 1365–1378. [Google Scholar] [CrossRef]
- Liu, Y.J.; Whelen, S.; Hall, B.D. Phylogenetic relationships among ascomycetes: Evidence from an RNA polymerse II subunit. Mol. Biol. Evol. 1999, 16, 1799–1808. [Google Scholar] [CrossRef]
- Kumar, S.; Tamura, K.; Jakobsen, I.; Nei, M. MEGA2: Molecular evolutionary genetics analysis software. Bioinformatics 2001, 17, 1244–1245. [Google Scholar] [CrossRef] [PubMed]
- Jaklitsch, W.M.; Voglmayr, H. Biodiversity of Trichoderma (Hypocreaceae) in Southern Europe and Macaronesia. Stud. Mycol. 2015, 80, 1–87. [Google Scholar] [CrossRef] [PubMed]
- Álvarez-García, S.; Mayo-Prieto, S.; Gutiérrez, S.; Casquero, P.A. Self-Inhibitory Activity of Trichoderma Soluble Metabolites and Their Antifungal Effects on Fusarium oxysporum. J. Fungi 2020, 6, 176. [Google Scholar] [CrossRef] [PubMed]
- Pehlivan, N.; Sun, L.; Jarrett, P.; Yang, X.; Mishra, N.; Chen, L.; Kadioglu, A.; Shen, G.; Zhang, H. Co-overexpressing a plasma membrane and a vacuolar membrane sodium/proton antiporter significantly improves salt tolerance in transgenic Arabidopsis plants. Plant Cell Physiol. 2016, 57, 1069–1084. [Google Scholar] [CrossRef] [PubMed]
- Pottorff, M.; Wanamaker, S.; Ma, Y.Q.; Ehlers, J.D.; Roberts, P.A.; Close, T.J. Genetic and physical mapping of candidate genes for resistance to Fusarium oxysporum f. sp. tracheiphilum race 3 in cowpea [Vigna unguiculata (L.) Walp]. PLoS ONE 2012, 7, e41600. [Google Scholar] [CrossRef]
- Sanogo, S.; Zhang, J. Resistance sources, resistance screening techniques and disease management for Fusarium wilt in cotton. Euphytica 2016, 207, 255–271. [Google Scholar] [CrossRef]
- Morton, M.; Awlia, M.; Al-Tamimi, N.; Saade, S.; Pailles, Y.; Negrão, S.; Tester, M. Salt stress under the scalpel-dissecting the genetics of salt tolerance. Plant J. 2019, 97, 148–163. [Google Scholar] [CrossRef]
- Maharshi, A.; Rashid, M.M.; Teli, B.; Yadav, S.K.; Singh, D.P.; Sarma, B.K. Salt stress alters pathogenic behaviour of Fusarium oxysporum f. sp. ciceris and contributes to severity in chickpea wilt incidence. Physiol. Mol. Plant Pathol. 2021, 113, 101602. [Google Scholar] [CrossRef]
- Triky-Dotan, S.; Yermiyahu, U.; Katan, J.; Gamliel, A. Development of crown and root rot disease of tomato under irrigation with saline water. Phytopathology 2005, 95, 1438–1444. [Google Scholar] [CrossRef]
- Harman, G.E.; Howell, C.R.; Viterbo, A.; Chet, I.; Lorito, M. Trichoderma species-opportunistic, avirulent plant symbionts. Nat. Rev. Microbiol. 2004, 2, 43–56. [Google Scholar] [CrossRef]
- Mendoza-Mendoza, A.; Zaid, R.; Lawry, R.; Hermosa, R.; Monte, E.; Horwitz, B.A.; Mukherjee, P.K. Molecular dialogues between Trichoderma and roots: Role of the fungal secretome. Fungal Biol. Rev. 2018, 32, 62–85. [Google Scholar] [CrossRef]
- Boamah, S.; Zhang, S.; Xu, B.; Li, T.; Calderón-Urrea, A. Trichoderma longibrachiatum (TG1) Enhances Wheat Seedlings Tolerance to Salt Stress and Resistance to Fusarium pseudograminearum. Front. Plant Sci. 2021, 12, 741231. [Google Scholar] [CrossRef] [PubMed]
- Jiang, Y.; Wang, J.; Chen, J.; Mao, L.; Feng, X.; Zhang, C.; Lin, F. Trichoderma biodiversity of agricultural fields in east china reveals a gradient distribution of species. PLoS ONE 2016, 11, e160613. [Google Scholar] [CrossRef]
- Mareick, R.; Blaszczyk, L.; Biegańska-Marecik, R.; Piotrowska-Cyplik, A. Screening and identification of Trichoderma strains isolated from natural habitats with potential to cellulose and xylan degrading enzymes production. Pol. J. Microbiol. 2018, 67, 181–190. [Google Scholar] [CrossRef] [PubMed]
- Khan, R.A.A.; Najeeb, S.; Hussain, S.; Xie, B.; Li, Y. Bioactive secondary metabolites from Trichoderma spp. against phytopathogenic fungi. Microorganisms 2020, 8, 817. [Google Scholar] [CrossRef] [PubMed]
- Zhang, S.; Xu, B.; Zhang, J.; Gan, Y. Identification of the antifungal activity of Trichoderma longibrachiatum T6 and assessment of bioactive substances in controlling phytopathgens. Pestic. Biochem. Physiol. 2018, 147, 59–66. [Google Scholar] [CrossRef]
- Alwadai, A.S.; Perveen, K.; Alwahaibi, M. The isolation and characterization of antagonist Trichoderma spp. from the soil of Abha, Saudi arabia. Molecules 2022, 27, 2525. [Google Scholar] [CrossRef]
- Chen, J.; Zhou, L.; Din, I.U.; Arafat, Y.; Li, Q.; Wang, J.; Wu, T.; Wu, L.; Wu, H.; Qin, X.; et al. Antagonistic Activity of Trichoderma spp. Against Fusarium oxysporum in Rhizosphere of Radix pseudostellariae Triggers the Expression of Host Defense Genes and Improves Its Growth Under Long-Term Monoculture System. Front. Microbiol. 2021, 12, 579920. [Google Scholar] [CrossRef]
- Guzmán-Guzmán, P.; Porras-Troncoso, M.D.; Olmedo-Monfil, V.; Herrera-Estrella, A. Trichoderma species: Versatile plant symbionts. Phytopathology 2018, 109, 6–16. [Google Scholar] [CrossRef]
- Akhtar, M.N.; Singh, R.P.; Kumar, S.; Tewari, R. Optimization of delivery systems to improve plant growth and to manage wilt and rot of tomato through Trichoderma harzianum PBAT-21. J. Plant Pathol. 2017, 3, 275–281. [Google Scholar]
- Alfiky, A.; Weisskopf, L. Deciphering Trichoderma-plant-pathogen interactions for better development of biocontrol applications. J. Fungi 2021, 7, 61. [Google Scholar] [CrossRef] [PubMed]
- Soussi, M.; Ocaña, A.; Lluch, C. Effects of salt stress on growth, photosynthesis and nitrogen fixation in chick-pea (Cicer arietinum L.). J. Exp. Bot. 1998, 49, 1329–1337. [Google Scholar] [CrossRef]
- Singh, S.P.; Pandey, S.; Mishra, N.; Giri, V.P.; Mahfooz, S.; Bhattacharya, A.; Kumari, M.; Chauhan, P.; Verma, P.; Nautiyal, C.S.; et al. Supplementation of Trichoderma improves the alteration of nutrient allocation and transporter genes expression in rice under nutrient deficiencies. Plant Physiol. Biochem. 2019, 143, 351–363. [Google Scholar] [CrossRef]
- Wang, Y.; Shen, W.; Chan, Z.; Wu, Y. Endogenous cytokinin overproduction modulates ROS homeostasis and decreases salt stress resistance in Arabidopsis thaliana. Front. Plant Sci. 2015, 6, 1004. [Google Scholar] [CrossRef]
- Oprica, L.; Vicente, O.; Boscaiu, M.; Grigore, M. Enzymatic activity and soluble protein content in seedlings of Calendula officinalis L. under salt stress. J. Plant Dev. 2016, 23, 71–79. [Google Scholar]
- Zhang, F.; Wang, Y.; Liu, C.; Chen, F.; Ge, H.; Tian, F.; Yang, T.; Ma, K.; Zhang, Y. Trichoderma harzianum mitigates salt stress in cucumber via multiple responses. Ecotoxicol. Environ. Saf. 2019, 170, 436–445. [Google Scholar] [CrossRef]
- Yu, W.; Yu, Y.; Wang, C.; Zhang, Z.; Xue, Z. Mechanism by which salt stress induces physiological responses and regulates tanshinone synthesis. Plant Physiol. Biochem. 2021, 164, 10–20. [Google Scholar] [CrossRef]
- Abdelrahman, M.; Abdel-Motaal, F.; El-Sayed, M.; Jogaiah, S.; Shigyo, M.; Ito, S.; Tran, L. Dissection of Trichoderma longibrachiatum induced defense in onion (Allium cepa L.) against Fusarium oxysporum f. sp. cepa by target metabolite profiling. Plant Sci. 2016, 246, 128–138. [Google Scholar] [CrossRef]
- Sousa, T.P.D.; Chaibub, A.A.; Silva, G.B.D.; Filippi, M.C.C.D. Trichoderma asperellum modulates defense genes and potentiates gas exchanges in upland rice plants. Physiol. Mol. Plant Pathol. 2020, 112, 101561. [Google Scholar] [CrossRef]
- Meng, Y.; Yin, Q.; Yan, Z.; Wang, Y.; Niu, J.; Zhang, J.; Fan, K. Exogenous silicon enhanced salt resistance by maintaining K+/Na+ homeostasis and antioxidant performance in Alfalfa leaves. Front. Plant Sci. 2020, 11, 1183. [Google Scholar] [CrossRef]
- Coppola, M.; Cascone, P.; Lelio, I.D.; Woo, S.L.; Lorito, M.; Rao, R.; Pennacchio, F.; Guerrieri, E.; Digilio, M.C. Trichoderma atroviride P1 colonization of tomato plants enhances both direct and indirect defense barriers against insects. Front. Physiol. 2019, 10, 813. [Google Scholar] [CrossRef] [PubMed]
- Carro-Huerga, G.; Compant, S.; Gorfer, M.; Cardoza, R.E.; Schmoll, M.; Gutiérrez, S.; Casquero, P.A. Colonization of Vitis vinifera L. by the endophyte Trichoderma sp. strain T154: Biocontrol activity against Phaeoacremonium minimum. Front. Plant Sci. 2020, 11, 1170. [Google Scholar] [CrossRef] [PubMed]
- Hafiz, F.B.; Moradtalab, N.; Goertz, S.; Rietz, S.; Dietel, K.; Rozhon, W.; Humbeck, K.; Geistlinger, J.; Neumann, G.; Schellenberg, I. Synergistic effects of a root-endophytic Trichoderma fungus and Bacillus on early root colonization and defense activation against Verticillium longisporum in rapeseed. Mol. Plant Microbe Interact. 2022, 35, 380–392. [Google Scholar] [CrossRef] [PubMed]
- Badiwe, M.; Rafudeen, M.; Klein, A. The influence of Fusarium oxysporum infection on the physiological and biochemical responses of cowpea seedlings. S. Afr. J. Bot. 2018, 115, 315–316. [Google Scholar] [CrossRef]
- Smolińska, U.; Kowalska, B.; Oskiera, M. The effectivity of Trichoderma strains in the protection of cucumber and lettuce against Rhizoctonia solani. Veg. Crops Res. Bull. 2007, 67, 81–93. [Google Scholar] [CrossRef]
- Zhang, S.; Xu, B.; Gan, Y. Seed treatment with Trichoderma longibrachiatum T6 promotes wheat seedling growth under NaCl stress through activating the enzymatic and nonenzymatic antioxidant defense systems. Int. J. Mol. Sci. 2019, 15, 3729. [Google Scholar] [CrossRef]

| Strain | Strain Number | RPB2 | TEF1 |
|---|---|---|---|
| Trichoderma longibrachiatum | TRS755 | KP009194.1 | KP008880.1 |
| Trichoderma longibrachiatum | TRS754 | KP009193.1 | KP008878.1 |
| Trichoderma longibrachiatum | TRS762 | KP009195.1 | KP008882.1 |
| Trichoderma citrinoviride | TRS751 | KP009189.1 | KP008893.1 |
| Trichoderma citrinoviride | TRS747 | KP009184.1 | KP008890.1 |
| Trichoderma britdaniae | 8020 | KJ634735.1 | KJ634768.1 |
| Trichoderma britdaniae | WU 31610 | JQ685880.1 | JQ685866.1 |
| Trichoderma tremelloides | CBS 121140 | FJ860603.1 | FJ860714.1 |
| Trichoderma ivoriense | BJ598-1 | MF774596.1 | MF774595.1 |
| Trichoderma rossicum | TRS445 | KP009080.1 | KP008967.1 |
| Trichoderma floccosum | TC633 | KX266251.1 | KX266245.1 |
| Trichoderma barbatum | TC700 | MF095877.1 | MF095873.1 |
| Trichoderma barbatum | SD1-13 | MF774594.1 | MF774593.1 |
| Trichoderma hebeiense | HMAS:248744 | KX344442.1 | KX344435.1 |
| Trichoderma hebeiense | HMAS:248743 | KX344439.1 | KX344434.1 |
| Trichoderma rossicum | TRS513 | KP009077.1 | KP008964.1 |
| Trichoderma rossicum | TRS514 | KP009078.1 | KP008965.1 |
| Trichoderma sichuanense | HMAS:248737 | KX344437.1 | KX344428.1 |
| Trichoderma verticillatum | HMAS:248742 | KX344444.1 | KX344433.1 |
| Trichoderma verticillatum | HMAS:248740 | KX344438.1 | KX344431.1 |
| Trichoderma reesei | G.J.S. 97-177 | HM182974.1 | GQ354347.1 |
| Protocrea farinosa | TFC 06-23 | EU703940.1 | EU703886.1 |
| Protocrea farinosa | TFC 97-168 | EU703941.1 | EU703896.1 |
| Protocrea pallida | TFC 99-238 | EU703945.1 | EU703903.1 |
| Medium with NaCl | ||||||||
|---|---|---|---|---|---|---|---|---|
| Strain | 0% (3 d) | 2% (3 d) | 4% (3 d) | 4% (7 d) | 6% (3 d) | 6% (7 d) | 8% (3 d) | 8% (7 d) |
| Diameter/Color | Diameter/Color | Diameter/Color | Diameter/Color | Diameter/Color | Diameter/Color | Diameter/Color | Diameter/Color | |
| HL167 | 8.5 ± 0.0/+++WG | 8.5 ± 0.0 a/+++LG | 8.4 ± 0.1 a/+++Y | 8.5 ± 0.0 a/+++LG | 5.1 ± 0.12 a/++W | 8 ± 0.1 a/+++YG | 3 ± 0.09 a/+W | 6.4 ± 0.1 a/+Y |
| HL169 | 8.5 ± 0.0/+++LG | 8.5 ± 0.0 a/+++G | 3.2 ± 0.3 m/+YG | 4.5 ± 0.1 j/+++G | 1 ± 0.13 j/+G | 1.6 ± 0.2 k/+LG | - | - |
| HL175 | 8.5 ± 0.0/+++G | 8.5 ± 0.0 a/+++G | 6.5 ± 0.1 e/++LG | 7.1 ± 0.04 e/+++G | 2 ± 0.09 g/+G | 4 ± 0.3 e/+G | - | - |
| HL158 | 8.5 ± 0.0/+++W | 8.5 ± 0.0 a/+++W | 3.6 ± 0.2 l/+LG | 4.1 ± 0.2 i/+LG | - | - | - | - |
| HL166 | 8.5 ± 0.0/+++LG | 8.5 ± 0.0 a/+++LG | 6 ± 0.1 hi/++YG | 8.2 ± 0.08 b/+++Y | 2.6 ± 0.04 de/+YG | 7 ± 0.1 b/++YG | 1.4 ± 0.01 b/+W | 4.4 ± 0.1 b/+Y |
| HL164 | 8.5 ± 0.0/+++WG | 8.5 ± 0.0 a/+++LG | 8 ± 0.1 b/+++G | 8.2 ± 0.05 b/+++LG | 3.4 ± 0.01 b/+LG | 7.1 ± 0.2 b/++G | 0.8 ± 0.08 d/+W | 2.2 ± 0.2 de/+LG |
| GS014 | 8.5 ± 0.0/+++LG | 8.5 ± 0.0 a/+++LG | 3.2 ± 0.1 m/++W | 3.9 ± 0.1 l/+G | - | - | - | - |
| GS044 | 8.5 ± 0.0/+++WG | 8.5 ± 0.0 a/+++G | 6.4 ± 0.1 ef/+W | 7.9 ± 0.02 c/+++G | 2.4 ± 0.0 f/+W | 7 ± 0.1 b/++YG | 1 ± 0.03 d/+W | 2 ± 0.1 ce/+W |
| QH031 | 8.5 ± 0.0/+++LG | 8.5 ± 0.0 a/+++LG | 4.2 ± 0.2 l/+YG | 6.8 ± 0.1 f/+++LG | 3 ± 0.12 c/+W | 6.7 ± 0.1 c/++G | 1 ± 0.07 d/+W | 1.8 ± 0.1 de/+W |
| QH100 | 8.5 ± 0.0/+++LG | 8.5 ± 0.0 a/+++LG | 7.4 ± 0.1 c/+G | 7.1 ± 0.1 e/+++LG | 1.6 ± 0.08 h/+W | 2.4 ± 0.2 i/+G | - | - |
| QH024 | 8.5 ± 0.0/+++LG | 8.5 ± 0.0 a/+++LG | 5 ± 0.3 k/++YG | 7.8 ± 0.02 c/+++LG | 3 ± 0.05 c/+LG | 7.3 ± 0.1 b/+++LG | 1.2 ± 0.2 c/+Y | 2.5 ± 0.03 c/+Y |
| NX002 | 8.5 ± 0.0/+++G | 5.1 ± 0.2 b/+W | 1 ± 0.1 o/+W | 2.1 ± 0.1 n/+Y | - | - | - | - |
| NX022 | 8.5 ± 0.0/+++G | 8.5 ± 0.0 a/+++G | 6.2 ± 0.2 fh/+G | 6.9 ± 0.01 f/+++G | 1.2 ± 0.08 i/+W | 2.2 ± 0.1 ij/+LG | - | - |
| NX004 | 8.5 ± 0.0/+++LG | 8.5 ± 0.0 a/+++LG | 4 ± 0.1 l/++W | 4.3 ± 0.1 k/+++LG | - | - | - | - |
| NX044 | 8.5 ± 0.0/+++YG | 8.5 ± 0.0 a/+++YG | 8.1 ± 0.1 b/+++G | 8.4 ± 0.09 a/+++Y | 2.4 ± 0.05 ef/+Y | 5 ± 0.1 d/+LG | - | - |
| NX050 | 8.5 ± 0.0/+++LG | 8.5 ± 0.0 a/+++G | 3.8 ± 0.3 l/+G | 5.3 ± 0.08 i/+++G | 0.6 ± 0.08 l/+Y | 2 ± 0.1 j/- | - | - |
| NX029 | 8.5 ± 0.0/+++G | 8.5 ± 0.0 a/+++G | 2.4 ± 0.3 n/+Y | 3.2 ± 0.2 m/+++G | 1.2 ± 0.12 d/+W | 2.4 ± 0.3 e/+Y | - | - |
| NX048 | 8.5 ± 0.0/+++LG | 8.5 ± 0.0 a/+++LG | 8.1 ± 0.1 b/+++G | 8.5 ± 0.0 a/+++LG | 2.4 ± 0.03 f/+LG | 7.1 ± 0.2 b/++YG | 0.9 ± 0.09 b/+W | 2.2 ± 0.1 a/+W |
| NX049 | 8.5 ± 0.0/+++G | 8.5 ± 0.0 a/+++G | 5.8 ± 0.2 n/++Y | 8.1 ± 0.09 i/+++G | 3.0 ± 0.05 c/+W | 6.5 ± 0.1 c/++LG | 1.4 ± 0.12 b/+W | 2.4 ± 0.2 c/+W |
| Treatment | Plant Height (cm) | Root Length (cm) | Chlorophyll a (mg·g−1 FW) | Chlorophyll b (mg·g−1 FW) | Total Chlorophyll (mg·g−1 FW) |
|---|---|---|---|---|---|
| CK | 26.5 ± 0.20 b | 12.9 ± 0.13 b | 1.97 ± 0.02 c | 0.60 ± 0.04 b | 2.57 ± 0.05 b |
| HL167 | 30.0 ± 0.16 a | 15.2 ± 0.21 a | 2.71 ± 0.02 a | 0.93 ± 0.05 a | 3.63 ± 0.04 a |
| 200mM NaCl | 17.5 ± 0.19 c | 9.1 ± 0.13 c | 1.58 ± 0.02 d | 0.48 ± 0.02 c | 2.06 ± 0.01 c |
| HL167 + NaCl | 24.5 ± 0.29 b | 11.1 ± 0.11 b | 2.10 ± 0.01 b | 0.57 ± 0.04 b | 2.68 ± 0.03 b |
| Treatment | June 2020 | July 2020 | July 2021 | |||
|---|---|---|---|---|---|---|
| Disease Index | Percent Control (%) | Disease Index | Percent Control (%) | Disease Index | Percent Control (%) | |
| CA-FO | 30.33 ± 3.72 c | 16.52 b | 25.67 ± 3.78 c | 34.18c | 21.17 ± 1.00 c | 27.82 c |
| CK-CK | 24.19 ± 2.24 b | - | 19.33 ± 3.21 ab | - | 20.67 ± 2.08 ab | - |
| FO-T | - | - | 22.67 ± 1.53 bc | 41.87b | 19.67 ± 1.53 ab | 32.94 b |
| CK-FO | 36.33 ± 4.09 d | - | 39.00 ± 4.36 d | - | 29.33 ± 2.31 d | - |
| T-FO | 17.87 ± 1.42 a | 50.81 a | 14.67 ± 1.53 a | 62.38a | 17.56 ± 0.96 a | 40.13 a |
Disclaimer/Publisher’s Note: The statements, opinions and data contained in all publications are solely those of the individual author(s) and contributor(s) and not of MDPI and/or the editor(s). MDPI and/or the editor(s) disclaim responsibility for any injury to people or property resulting from any ideas, methods, instructions or products referred to in the content. |
© 2023 by the authors. Licensee MDPI, Basel, Switzerland. This article is an open access article distributed under the terms and conditions of the Creative Commons Attribution (CC BY) license (https://creativecommons.org/licenses/by/4.0/).
Share and Cite
Liu, Z.; Xu, N.; Pang, Q.; Khan, R.A.A.; Xu, Q.; Wu, C.; Liu, T. A Salt-Tolerant Strain of Trichoderma longibrachiatum HL167 Is Effective in Alleviating Salt Stress, Promoting Plant Growth, and Managing Fusarium Wilt Disease in Cowpea. J. Fungi 2023, 9, 304. https://doi.org/10.3390/jof9030304
Liu Z, Xu N, Pang Q, Khan RAA, Xu Q, Wu C, Liu T. A Salt-Tolerant Strain of Trichoderma longibrachiatum HL167 Is Effective in Alleviating Salt Stress, Promoting Plant Growth, and Managing Fusarium Wilt Disease in Cowpea. Journal of Fungi. 2023; 9(3):304. https://doi.org/10.3390/jof9030304
Chicago/Turabian StyleLiu, Zhen, Ning Xu, Qiuying Pang, Raja Asad Ali Khan, Qiushi Xu, Cuidan Wu, and Tong Liu. 2023. "A Salt-Tolerant Strain of Trichoderma longibrachiatum HL167 Is Effective in Alleviating Salt Stress, Promoting Plant Growth, and Managing Fusarium Wilt Disease in Cowpea" Journal of Fungi 9, no. 3: 304. https://doi.org/10.3390/jof9030304
APA StyleLiu, Z., Xu, N., Pang, Q., Khan, R. A. A., Xu, Q., Wu, C., & Liu, T. (2023). A Salt-Tolerant Strain of Trichoderma longibrachiatum HL167 Is Effective in Alleviating Salt Stress, Promoting Plant Growth, and Managing Fusarium Wilt Disease in Cowpea. Journal of Fungi, 9(3), 304. https://doi.org/10.3390/jof9030304

